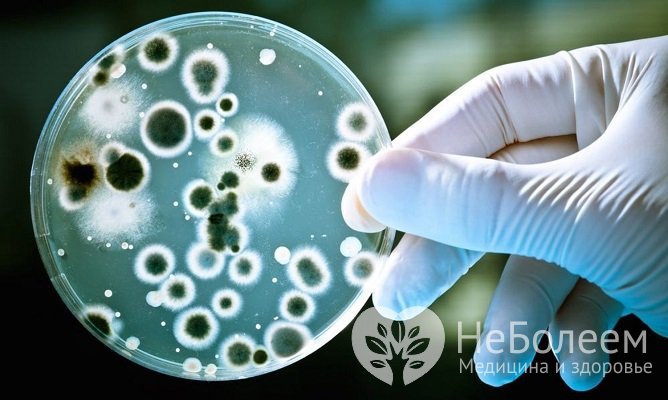
Антибиотики назначаются только в случаях, если возбудителем патологии являются бактерии

Воспользуйтесь поиском по сайту:
Лечение ларингита у детей в домашних условиях
Содержание статьи:
Лечение ларингита у детей в домашних условиях должно непременно проходить под наблюдением врача. Как правило, участковый педиатр посещает больного ребенка с определенной периодичностью и следит за состоянием в динамике.
 Лечение ларингита в домашних условиях должно проводиться по согласованию с врачом и под его контролем
Лечение ларингита в домашних условиях должно проводиться по согласованию с врачом и под его контролемЛарингит довольно часто диагностируется у детей и представляет собой воспалительное заболевание, поражающее слизистую оболочку гортани.
Острый ларингит чаще встречается в старшем детском возрасте. Симптомы могут развиваться как постепенно, так и быстро прогрессировать, вызывая стремительное ухудшение общего состояния. В зависимости от тяжести заболевания, температура тела может не повышаться или наоборот, доходить до фебрильных цифр (38,1–39 °C).
 Гортань при непрямой ларингоскопии
Гортань при непрямой ларингоскопииДля острого ларингита характерна гиперчувствительность гортани. Дети могут жаловаться на сухость, першение и жжение в горле. Появляется охриплость голоса, сухой мучительный судорожный кашель. При глотании возможны боли. Сухой кашель может сменяться влажным с отделением слизистой или слизисто-гнойной мокроты.
Причины и механизма развития ларингита
При изучении причин и механизма развития ларингита необходимо учитывать возрастные анатомо-физиологические особенности развития гортани у детей:
- гортань у детей раннего возраста расположена высоко, у мальчиков и девочек до 3 лет она имеет одинаковую длину;
- интенсивный рост гортани, голосовых и преддверных складок, надгортанника начинается с 4 лет;
- воронкообразная форма гортани начинает меняться на цилиндрическую с 5 лет;
- обилие лимфатических щелей и сосудов в гортани, большое количество тонкостенных кровеносных сосудов, слизистых желез, обширное скопление лимфоидной ткани характерно для детей всех возрастов;
- склонность гортани к судорогам и спазмам при раздражении объясняется лабильностью нервной системы у детей, преимущественно раннего возраста;
- воспалительный процесс в области носоглотки у детей раннего возраста очень быстро распространяется на гортань, что связано с малым расстоянием от ротовой полости до голосовой щели при высокорасположенной гортани;
- просвет гортани у детей узкий, а голосовые складки короткие, поэтому даже небольшое воспаление слизистой оболочки может привести к стенозу, значительно утяжеляя состояние ребенка;
- голосовые складки у детей до года более подвержены воспалительному и травматическому поражению из-за анатомической и физиологической незрелости.
 Развитию патологии способствует продолжительный крик или плач
Развитию патологии способствует продолжительный крик или плачПричиной развития воспаления гортани могут быть:
- вирусная, бактериальная или грибковая инфекция;
- острые и хронические воспалительные заболевания верхних и нижних дыхательных путей;
- бытовые травмы;
- наличие инородного тела;
- хирургические вмешательства;
- ожоги: химические, термические, электрические, лучевые;
- аллергия;
- вдыхание холодного воздуха;
- перенапряжение голосового аппарата;
- затрудненное носовое дыхание, при котором ребенок начинает дышать через рот;
- употребление холодных напитков;
- нарушение обмена веществ;
- заболевания желудочно-кишечного тракта;
- вегетоневрозы.
Под действием экзогенного или эндогенного раздражителя происходит воспаление слизистой оболочки гортани: появляется гиперемия, мелкоточечная инфильтрация, серозное пропитывание тканей. Увеличенное проникновение лейкоцитов через межэпителиальные пространства и усиленная работа слизистых желез способствуют разрывам, десквамации и частичному отторжению цилиндрического эпителия гортани.
Классификация
В зависимости от течения воспаления выделяют острый и хронический ларингит.
По распространенности воспалительного процесса острый ларингит может быть:
- диффузный, или разлитой;
- ограниченный.
Формы патологии по характеру течения:
- катаральная;
- стенозирующая;
- гиперпластическая, или гипертрофическая;
- атрофическая;
- геморрагическая;
- флегмонозная;
- дифтерийная.
Прежде чем начать прием любых лекарств, особенно антибактериальных, необходимо обратиться к врачу и подобрать схему терапии в зависимости от этиологического агента, вызвавшего воспаление.
В зависимости от этиологии, ларингит может быть:
- вирусный;
- бактериальный;
- грибковый, или ларингомикоз;
- травматический;
- аллергический.
Инфицирование гортани чаще всего происходит нисходящим путем при вдыхании загрязненного воздуха, воспалении носоглотки, придаточных пазух или миндалин. Также возможен восходящий путь – при трахеите, бронхите, пневмонии, туберкулезе.
Острый ларингит может быть проявлением многих инфекционных заболеваний (гриппа, кори, скарлатины и др.).
При несвоевременном или неадекватном лечении возможно развитие хронической формы болезни.
Читайте также:Самые полезные бытовые приборы для вашего здоровья
Аптекарский огород: лекарственные растения, которые можно вырастить на даче
12 лекарственных растений, способных причинить вред здоровью
Диагностика
Диагноз устанавливается врачом на основании данных осмотра, жалоб ребенка и родителей, результатов анализов и инструментального исследования.
 При необходимости назначается видеоэндостробоскопическое исследование гортани при помощи жесткого эндоскопа
При необходимости назначается видеоэндостробоскопическое исследование гортани при помощи жесткого эндоскопаОсновным методом диагностики является ларингоскопия. У детей раннего возраста проведение исследования может затруднять узкая желобоватая форма надгортанника. Современные фиброларингоскопы позволяют вывести изображение на экран и сделать запись видео.
При диффузной форме острого ларингита определяется рассеянная гиперемия и отек слизистой оболочки гортани. При ограниченной форме заболевания отмечается гиперемия и отек голосовых складок, межчерпаловидного и подголосового пространства. На поверхности слизистой оболочки видны расширенные кровеносные сосуды. В просвете гортани определяется вязкий слизисто-гнойный секрет. При фонации голосовые складки смыкаются не полностью, а голосовая щель имеет форму овала.
Доктор Комаровский и многие другие педиатры рекомендуют использовать народные средства только в дополнение к основной терапии, предварительно согласовав их с лечащим врачом.
Для выявления возбудителя инфекционного поражения проводится забор отделяемого со слизистой оболочки гортани. Бактериологический посев позволяет определить чувствительность к действию антибиотиков.
С целью исключения бронхопневмонии может назначаться рентгенография органов грудной клетки.
Лечение ларингита у детей
Как лечить ларингит у ребенка 2 лет и младше? Как эффективно и безопасно вылечить ларингит у ребенка 3 лет и старше? Для того чтобы разобрать данные вопросы, нужно учесть не только возрастные особенности, но и форму ларингита, общее состояние организма, наличие сопутствующей соматической патологии.
Общие рекомендации для лечения в домашних условиях, независимо от возраста ребенка:
- постельный режим;
- голосовой покой;
- исключение раздражающих напитков и пищи;
- обильное теплое питье;
- щелочные минеральные воды.
Применяют отвлекающие процедуры: горячие ножные ванны или горчичники на икры.
 При кашле эффективно применение корня алтея
При кашле эффективно применение корня алтеяДля облегчения кашля назначают отхаркивающие препараты (корень алтея, Гербион, Лазолван). Недопустимо принимать одновременно отхаркивающие и противокашлевые средства.
Среди фитопрепаратов рекомендуется применять Тонзилгон Н, содержащий отхаркивающие сборы (корень алтея, цветы ромашки, одуванчик, сосновые почки). Препарат обладает противовоспалительным свойством, уменьшает отек слизистой оболочки дыхательных путей. За счет нормализации работы лимфоцитов оказывает иммуностимулирующее действие.
При подозрении на бактериальное поражение важную роль играет этиотропное лечение. Учитывая глобальное распространение антибиотикорезистентности возбудителей инфекций, к применению антибиотиков нужно подходить серьезно.
Антибиотики назначаются только в случаях, если возбудителем патологии являются бактерии
Антибиотики назначаются только в случаях, если возбудителем патологии являются бактерииПрежде чем начать прием любых лекарств, особенно антибактериальных, необходимо обратиться к врачу и подобрать схему терапии в зависимости от этиологического агента, вызвавшего воспаление.
Продолжительность антибактериального лечения в среднем составляет 7–10 дней. В зависимости от предполагаемого возбудителя, назначают защищенные пенициллины, цефалоспорины, макролиды.
Для уменьшения отека тканей применяют антигистаминные препараты (Супрастин, Тавегил).
Аскорбиновая кислота показана с целью укрепления сосудистой стенки, а витамины группы В – для улучшения состояния нервной системы.
По показаниям врач может назначить глюкокортикоидные препараты (Дексаметазон).
В условиях стационара проводится местное лечение, включающее вливания в гортань эмульсии из персикового масла, гидрокортизона и антибактериального препарата.
Среди физиотерапевтических процедур положительный эффект оказывают:
- ингаляции увлажненного кислорода;
- вливания в гортань трипсина и химотрипсина;
- электрофорез гиалуронидазы или 1% калия йодида;
- воздействие терапевтического лазера на область гортани.
При воспалении тканей гортани возможен стеноз, сопровождающийся затруднением или даже невозможностью дыхания. Он возникает из-за отека и инфильтрации слизистой оболочки гортани и трахеи, спазма мышц и гиперсекреции желез со скоплением в просвете гортани слизисто-гнойного отделяемого.
У ребенка появляется лающий кашель, одышка на вдохе, кожные покровы и видимые слизистые оболочки бледнеют, отмечается синюшность носогубного треугольника, пальцев.
Инфицирование гортани чаще всего происходит нисходящим путем при вдыхании загрязненного воздуха, воспалении носоглотки, придаточных пазух или миндалин. Также возможен восходящий путь – при трахеите, бронхите, пневмонии, туберкулезе.
Что делать при развитии неотложного состояния при специфическом и неспецифическом ларингите?
Оказание первой помощи при ларингите у детей в домашних условиях в случае развития стеноза гортани включает следующие пункты:
- вызвать скорую помощь;
- обеспечить максимальный приток воздуха в помещение;
- помочь ребенку принять положение сидя (для участия вспомогательной мускулатуры в акте дыхания);
- освободить от стесняющей одежды.
 При неотложном состоянии родители до приезда врачей должны оказать первую помощь
При неотложном состоянии родители до приезда врачей должны оказать первую помощьПри легкой степени приступа часто дают теплое щелочное питье, при лихорадке – парацетамол или ибупрофен (внутрь или ректально).
Хорошо помогают ингаляции суспензии будесонида через компрессорный небулайзер.
Судя по положительным отзывам и рекомендациям врачей, одним из эффективных препаратов является Беродуал. Он оказывает противовоспалительное и спазмолитическое действие, нормализует секрецию слизистых желез. Для ингаляций рекомендуется использовать небулайзер. В результате процедуры у ребенка уменьшается кашель, облегчается дыхание.
Доктор Комаровский и многие другие педиатры рекомендуют использовать народные средства только в дополнение к основной терапии, предварительно согласовав их с лечащим врачом. Противовоспалительное действие оказывают:
- экстракт ромашки;
- кора дуба;
- листья ореха;
- трава тысячелистника.
Видео
Предлагаем к просмотру видеоролик по теме статьи.
Об авторе

Опыт работы: 4 года работы в частной практике.
Нашли ошибку в тексте? Выделите ее и нажмите Ctrl + Enter.
Средняя продолжительность жизни левшей меньше, чем правшей.
























